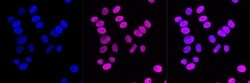
Invitrogen CAF1 p150 Recombinant Rabbit Monoclonal Antibody (23GB1060),

missing translation for 'onlineSavingsMsg'
Learn More
Learn More
Invitrogen™ CAF1 p150 Recombinant Rabbit Monoclonal Antibody (23GB1060), Invitrogen™
Rabbit Recombinant Monoclonal Antibody
Brand: Invitrogen™ MA553299
This item is not returnable.
View return policy
Description
CAF1 p150 is part of the chromatin assembly factor 1 (CAF-1) complex, a key player in DNA repair and replication processes. CAF-1, composed of p150 (CHAF1A), p60 (CHAF1B), and p48 subunits, functions primarily in the deposition of newly synthesized histones H3 and H4 onto nascent DNA strands, ensuring chromatin is properly assembled during DNA replication and after repair. The p150 subunit is the largest of the CAF-1 complex and is critical for binding DNA and recruiting CAF-1 to replication sites, facilitating histone deposition in a process vital for maintaining genome stability and epigenetic inheritance. Beyond just chromatin formation, CAF1 p150 is involved in influencing gene silencing and the maintenance of heterochromatin, impacting gene regulation notably during development and in response to DNA damage. Its role has implications in oncogenesis, where dysregulation of CAF1 p150 can lead to altered chromatin structures and contribute to tumorigenesis, marking it as an important target in cancer research.
Specifications
| CAF1 p150 | |
| Recombinant Monoclonal | |
| Unconjugated | |
| CHAF1A | |
| AL023013; AL024058; Cac1p; CAF; CAF1; CAF-1; CAF-1 subunit A; CAF1B; CAF1P150; CAF-I 150 kDa subunit; CAF-I p150; CAF-Ip150; Caip150; CHAF1A; Chromatin assembly factor 1 subunit A; chromatin assembly factor 1, subunit A (p150); chromatin assembly factor I (150 kDa); chromatin assembly factor I p150 subunit; CTB-50L17.7; hp150; MGC71229; P150 | |
| Rabbit | |
| Affinity chromatography | |
| RUO | |
| 10036 | |
| -20°C | |
| Liquid |
| Flow Cytometry, Western Blot, Immunocytochemistry | |
| 23GB1060 | |
| PBS with 50% glycerol and 0.02% sodium azide; pH 7.4 | |
| Q13111 | |
| CHAF1A | |
| A synthetic peptide of human p150 CAF1 (121-134AA). | |
| 20 μL | |
| Primary | |
| Human | |
| Antibody | |
| IgG |
Product Content Correction
Your input is important to us. Please complete this form to provide feedback related to the content on this product.
Product Title
Spot an opportunity for improvement?Share a Content Correction